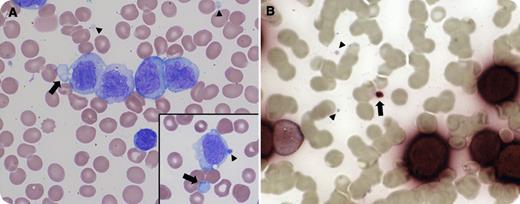
A 19-year-old man presented with fever and gum pain for 2 weeks. Physical examination revealed pallor, gingival hyperplasia, and cervical and axillary lymphadenopathy. Automated blood count demonstrated 115 × 103/mm3 white blood cells, 10.7 g/dL of hemoglobin, hematocrit 31.5%, and 42 × 103/mm3 platelets. Peripheral blood smear revealed 85% monoblasts and promonocytes (blast equivalents) as well as cytoplasmic leukemic cell fragments (arrows) mimicking platelets (arrowheads) (panel A and inset). The blasts and “pseudoplatelets” (arrow) stained for nonspecific esterase, confirming their monocytic leukemic origin, whereas platelets (arrowheads) were negative (panel B). The pseudoplatelets accounted for 20% of the platelets counted by the automated counter. Flow cytometry confirmed the diagnosis of acute monocytic leukemia. / A spuriously elevated platelet count resulting from leukemic cell fragmentation can be seen in almost all subtypes of acute myeloid leukemia (AML) as well as acute lymphoblastic leukemia, but it is particularly associated with AML with maturation and with acute monoblastic and monocytic leukemias. Therefore, platelet counts obtained by an automated counter may overestimate the true platelet count. Clinicians and pathologists should evaluate the peripheral blood smear visually at diagnosis and before invasive diagnostic and therapeutic interventions to minimize bleeding risk.

A 19-year-old man presented with fever and gum pain for 2 weeks. Physical examination revealed pallor, gingival hyperplasia, and cervical and axillary lymphadenopathy. Automated blood count demonstrated 115 × 103/mm3 white blood cells, 10.7 g/dL of hemoglobin, hematocrit 31.5%, and 42 × 103/mm3 platelets. Peripheral blood smear revealed 85% monoblasts and promonocytes (blast equivalents) as well as cytoplasmic leukemic cell fragments (arrows) mimicking platelets (arrowheads) (panel A and inset). The blasts and “pseudoplatelets” (arrow) stained for nonspecific esterase, confirming their monocytic leukemic origin, whereas platelets (arrowheads) were negative (panel B). The pseudoplatelets accounted for 20% of the platelets counted by the automated counter. Flow cytometry confirmed the diagnosis of acute monocytic leukemia.
A spuriously elevated platelet count resulting from leukemic cell fragmentation can be seen in almost all subtypes of acute myeloid leukemia (AML) as well as acute lymphoblastic leukemia, but it is particularly associated with AML with maturation and with acute monoblastic and monocytic leukemias. Therefore, platelet counts obtained by an automated counter may overestimate the true platelet count. Clinicians and pathologists should evaluate the peripheral blood smear visually at diagnosis and before invasive diagnostic and therapeutic interventions to minimize bleeding risk.
A 19-year-old man presented with fever and gum pain for 2 weeks. Physical examination revealed pallor, gingival hyperplasia, and cervical and axillary lymphadenopathy. Automated blood count demonstrated 115 × 103/mm3 white blood cells, 10.7 g/dL of hemoglobin, hematocrit 31.5%, and 42 × 103/mm3 platelets. Peripheral blood smear revealed 85% monoblasts and promonocytes (blast equivalents) as well as cytoplasmic leukemic cell fragments (arrows) mimicking platelets (arrowheads) (panel A and inset). The blasts and “pseudoplatelets” (arrow) stained for nonspecific esterase, confirming their monocytic leukemic origin, whereas platelets (arrowheads) were negative (panel B). The pseudoplatelets accounted for 20% of the platelets counted by the automated counter. Flow cytometry confirmed the diagnosis of acute monocytic leukemia.
A spuriously elevated platelet count resulting from leukemic cell fragmentation can be seen in almost all subtypes of acute myeloid leukemia (AML) as well as acute lymphoblastic leukemia, but it is particularly associated with AML with maturation and with acute monoblastic and monocytic leukemias. Therefore, platelet counts obtained by an automated counter may overestimate the true platelet count. Clinicians and pathologists should evaluate the peripheral blood smear visually at diagnosis and before invasive diagnostic and therapeutic interventions to minimize bleeding risk.
For additional images, visit the ASH IMAGE BANK, a reference and teaching tool that is continually updated with new atlas and case study images. For more information visit http://imagebank.hematology.org.

This feature is available to Subscribers Only
Sign In or Create an Account Close Modal